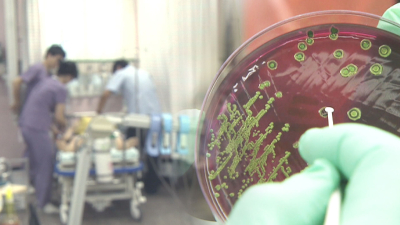

<9/13(목) 모닝730 이어서+조간브리핑>
【 앵커멘트 】 9월 13일 목요일 아침신문 살펴보겠습니다. 【 기자 】 1. 경향신문입니다. 발달장애를 겪는 아이들을 위한 장애아 전문 어린이집과 특수학교가 대폭 늘어난다는 기삽니다. 장애아 전문 어린이집은 12명 이상의 장애아가 다니는 시설로, 교사 3명 중 1명은 특수교사가 배치됩니다. 정부는 2022년까지 장애아 전문 어린이집과 통합 어린이집 60곳을 새로 만들어, 발달장애아들의 보육을 돕겠다고 밝혔습니다. 또 장애아를 위한 초.중 특수학교도,현재 170여 개에서 5년 안에 190여 개로 늘리
2018-09-13